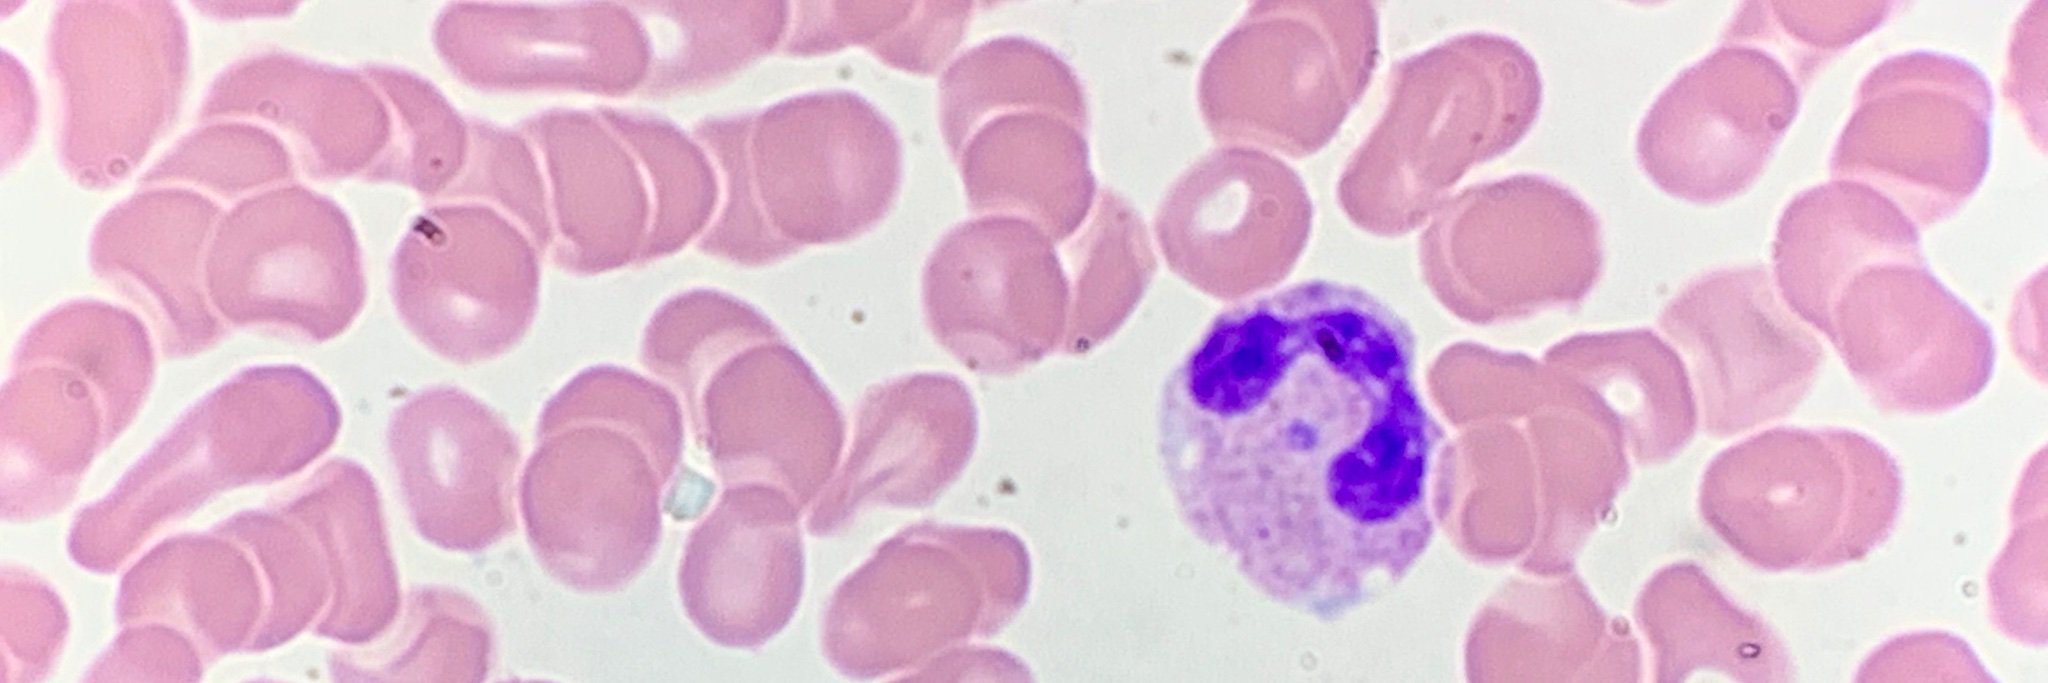
@smdh@mastodon.world banner

2.1K posts


@PathologyPatty
Mother. Wife. Sister. Friend. MD. Lab Medicine. Opinions mine, T/RT≠ medical advice. Kindness and compassion ≠ weakness.
In the clinical lab. Katılım Mayıs 2009
1.6K Takip Edilen653 Takipçiler
Henüz tweet yok
2.1K posts

@PathologyPatty
Mother. Wife. Sister. Friend. MD. Lab Medicine. Opinions mine, T/RT≠ medical advice. Kindness and compassion ≠ weakness.
Henüz tweet yok